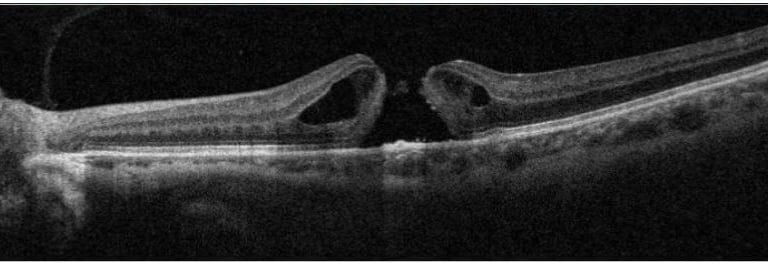
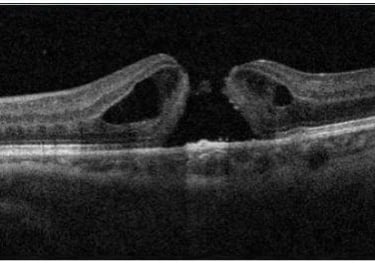

Doenças Oftalmológicas
Nesta seção, explicamos as doenças oculares mais prevalentes de forma clara e acessível. Nosso objetivo é ajudar você a entender as causas, sintomas e tratamentos de condições como catarata, glaucoma, degeneração macular e outras. Com informações simples e diretas, queremos que você se sinta informado e confiante para cuidar da sua saúde ocular. Caso tenha dúvidas, nossa equipe está à disposição para ajudar.
Retinopatia Diabética
Degeneração Macular Relacionada a Idade (DMRI)




Oclusões Vasculares da retina
Visão
Cuidado personalizado para sua saúde ocular.
Clínica
Exames
+55 27 98111-6752
© 2024. All rights reserved.
+55 27 3336-5925